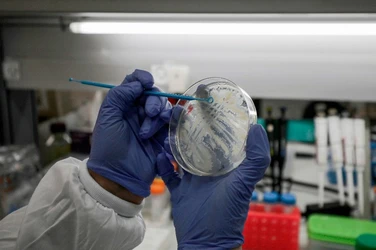

San Cristóbal De Las Casas, Chis. El titular de la Secretaría de Salud estatal, José Manuel Cruz Castellanos, confirmó ayer que se detectó el primer caso de Covid-19 (coronavirus) en Chiapas.
En conferencia de prensa, explicó que la enferma es una joven de 18 años de edad que se encontraba estudiando en Milán, Italia, con otra compañera, quien también dio positivo al virus en Torreón, Coahuila.
Se hizo una primera prueba en nuestro laboratorio, que es de primer nivel, y resultó positiva. La noche del sábado se enviaron los resultados al Instituto Nacional de Enfermedades Respiratorias, y lo confirmó
, agregó Cruz Castellanos. Señaló que la joven fue visitada en su casa y manifestó que comenzó con los síntomas el pasado 24 de febrero.
Puntualizó que se trata de un caso asintomático
, a quien se le identificaron 14 contactos posteriores a su llegada a México, todos los cuales también se hallaban asintomáticos y no han requerido atención médica ni hospitalización
.
De acuerdo con Cruz Castellanos, este caso no significa que haya transmisión del virus en Chiapas, dado que es importado y que por ser asintomático el riesgo de contagio a otras personas disminuye considerablemente.
Destacó que por lo pronto, ninguna de las personas con las que la joven ha tenido contacto recientemente tienen alguna sintomatología asociada a coronavirus, pero se continuará con el periodo de vigilancia por 14 días hasta tener la certeza de que no hay trasmisión.
Por separado, el gobernador Rutilio Escandón Cadenas aseguró en su cuenta de Twitter que la paciente se encuentra ya en etapa asintomática y recibiendo la atención necesaria
. Añadió que hemos seguido todos los protocolos de contención
y la situación está bajo control
, además que pidió a la población atender las recomendaciones sanitarias.
Juan Manuel Cruz, quien fue acompañado por representantes del sector salud estatal, aseguró que la entidad está preparada para atender casos de Covid-19, ya que cuenta con un sistema de vigilancia epidemiológica fortalecido
.
Sospechosos en Veracruz
En tanto, la Secretaría de Salud de Veracruz dio a conocer que el Laboratorio Estatal de Salud Pública analizó tres casos sospechosos de coronavirus. Indicó que uno de ellos resultó negativo, y envió los otros dos al Instituto Nacional de Referencia Epidemiológica para estudios finales.
Precisó que los posibles afectados son una mujer y un varón de 27 y 22 años de edad residentes en Xalapa.
(Con información de Notimex).